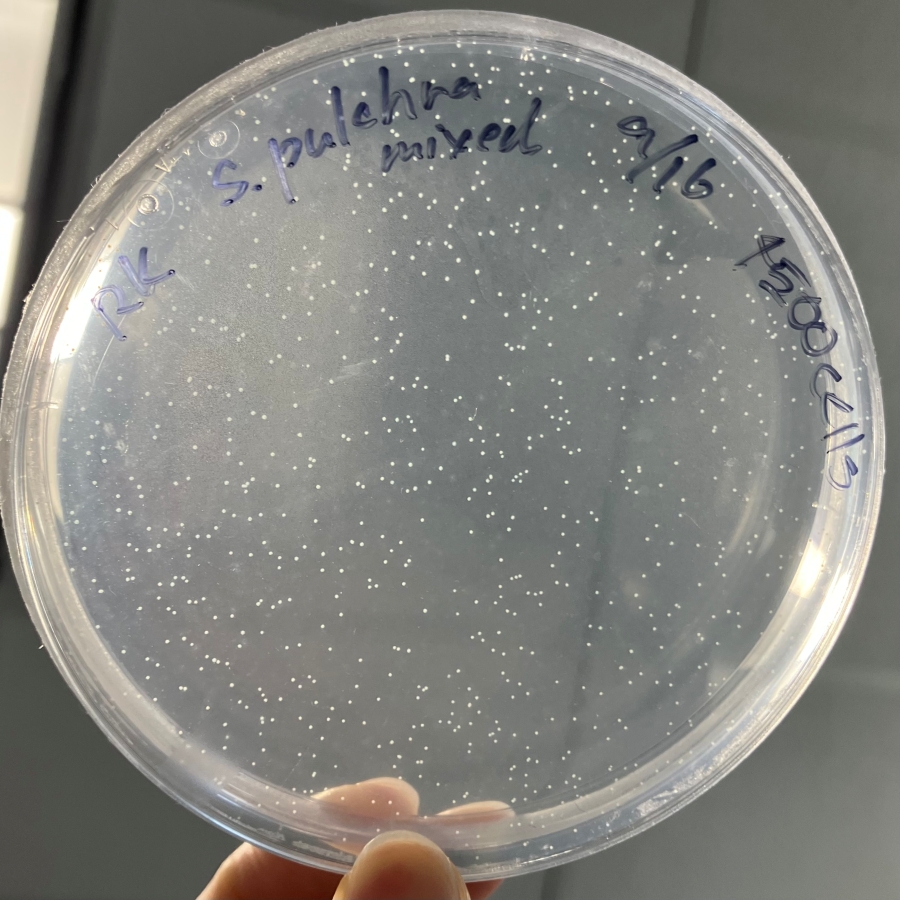

海外留学・国際交流 2025年度 サンマルコス研修レポート
サンマルコス研修レポート①
生命科学研究科 生命エネルギー工学研究室 修士1年 小森谷瑠菜
1週目(8月23日〜29日)
日本から約11時間のフライトを経て、サンディエゴ空港に到着しました。現在、空港は改修工事中で、9月に完成予定とのことです。帰国時には新しいターミナルから出発できそうです。
ホームステイ先は、留学先であるカリフォルニア州立大学サンマルコス校(CSUSM)の教授ご夫妻のお宅です。二人ともとても優しくたくさん話しかけてくれます。日本の住宅とは異なり、平屋でとても広く、暖炉もある素敵なお家です。犬を二匹飼っていて、人懐っこく、部屋に遊びに来てくれることもあります。家にはクレープメーカーがあり、初めてクレープ作りに挑戦しました。生地を薄く丸く広げるのが難しく、今週2回挑戦しましたがきれいな円になりませんでした。こちらでは、クレープを半分に折りたたんでフォークで食べます。ホストマザーおすすめのヌテラバナナクレープはとても美味しかったです。
到着2日目には、ホストファミリーとその親戚の方々と一緒にピクニックへ出かけました。公園ではバンド演奏があり、多くの人と犬で賑わっていました。日本に比べ大型犬が多いのが印象的でした。午後5時ごろでしたが日差しが強く、日向は暑かったです。しかし陽が落ちてくると一気に涼しくなり、半袖では肌寒く感じるほどでした。親戚の方の一人は日本で働いた経験があり、日本語の挨拶をしてくださるなど、日本に深い関心を持っている方でした。来年は四国で3か月かけてお遍路をされるそうです。

ピクニックで食べたサンドイッチ

ピクニックの様子
大学キャンパスは非常に広大で、初日のキャンパスツアーでは長い距離を歩きました。キャンパス内には道路が整備されており、目的の建物の近くまで車で移動することもできます。私もホストファミリーに送り迎えをしていただいています。カリフォルニアは山や丘が多く、起伏に富んだキャンパスは、東京薬科大学の環境とどこか似ていると感じました。

キャンパスの様子
授業は大学院講義と英語を履修しています。大学院講義は難易度が高く、理解が追いつかない部分も多かったですが、先生方はとても親切で、授業前後に声をかけてくださったり、他の学生に紹介してくださったりしました。英語の授業は留学生向けで、日本から短期留学している学生とも仲良くなれました。空き時間には、キャンパス内の娯楽施設で一緒にビリヤードやUNOを楽しんだり、交代でピアノを弾いたりしました。CSUSMの学生さんに日本の「かえるのうた」と輪唱を紹介したり、みんなでアメリカの童謡を歌ったりしました。また、昼食を買いに行った際、店員さんがカタコトの日本語で話しかけてくれる場面もあり、異文化交流の楽しさを実感しました。私もつられてカタコトの日本語を話してしまいました。今後はネイティブらしく話そうと思います。

通学の車内では、ホストファザーが発音を指導してくださいました。特に日本人が苦手とする “water” の発音について教えていただき、何度も一緒に練習していますがまだ数回しか合格を貰えていません。来週には習得を目指したいと思います。
週末には、日本人留学生と一緒にLAツアーに参加しました。ハリウッドでは有名人の手形や足形を見たり、レッドカーペットが敷かれる場所で記念写真を撮ったりしました。日本人で唯一手形を残しているのはX JAPANのYOSHIKIさんです。私は普段あまり海外作品を見ることはないですが、そんな私でも知っている名だたるスターたちの手形や足形がたくさんありました。サンタモニカでは海を眺めたりショッピングを楽しんだり、アメリカらしい一日を満喫しました。昼食は初めてレストランで取りましたが、担当のウェイターが途中で見当たらなくなり、会計に30分以上かかるというハプニングもありました。慣れないシステムに戸惑いながらも、自分たちだけでレストランに行くという貴重な経験になりました。

サンタモニカビーチの様子

YOSHIKIさんの手形
サンマルコス研修レポート②
2週目(8月30日〜9月5日)
2週目の月曜日は「Labor Day」という祝日で、毎年9月の第一月曜日にあたります。連休ということもあり、ホストファミリーのご親族が集まり、ラホヤビーチで食事を楽しみました。
「La Jolla(ラホヤ)」はスペイン語で“宝石”を意味し、美しい海岸線に野生のアザラシやペリカンが見られるリゾート地です。対岸には結婚式場があり、ホストファミリーはそこで結婚式を挙げたと教えてくれました。

当日は多くの人々がビーチで夏を満喫しており、ホストファミリーはカヤックを楽しんでいました。周辺には飲食店やギャラリー、アパレルショップや雑貨店が立ち並び、歩いているだけでも楽しい場所でした。連休中ということもあり混雑しており、駐車場を見つけるまでに20分ほどかかりました。
また、テニスや卓球に似た「ピックルボール」というスポーツにも挑戦しました。穴の開いたボールを使うため球速があまり速くならず、初心者でも楽しめるスポーツです。コートの広さはバドミントン程度で、幅広い年代に親しまれています。久しぶりに走ったため夜には筋肉痛になりましたが、「またやろうね!」と声をかけてもらえたので、次回は少し上達できるように頑張りたいと思います。

ホームステイ先のご近所のお宅にもお邪魔しました。近所付き合いが盛んで、犬の散歩中にもすれ違う人に手を振ったり挨拶を交わしたりする光景が日常的です。お隣の方は長く日本に住んでいた経験があり、流暢な日本語を話されます。私のために英語で話しかけてくださいますが、理解が難しい時には日本語でサポートしていただけました。日本食が好きで常に家に常備されており、この日は味噌ラーメンと餃子をご馳走になりました。久しぶりの日本食は安心感のある味でした。
休み明けからは新しい講義も始まりました。半導体企業の会長による講演を聞く機会や、先週からスタートしたビジネスの講義に参加しました。印象的だったのは、講義中の積極的な質問です。会長の講演では参加者の半数近くが挙手し、全員が質問できないほどでした。講義後も質問できなかった学生が一斉に話しかけに行く様子から、積極性の高さを感じました。通常の授業でも教授の問いかけに必ず誰かが反応し、意見や疑問があれば自由に発言する雰囲気があります。日本では問いに対して発言が少ないことが多く、一人が意見を言ってしまうと、それ以上発言が出ないことも少なくないですが、各々が意見を出し合える雰囲気が素敵だと感じました。
私はまだ内容をすべて理解できるわけではありませんが、グループディスカッションに参加する機会がありました。同じグループの学生がとても親切で、私にも理解できるように協力してくれました。先週はあまり交友関係を広げられませんでしたが、今週はキャンパス内で声をかけてもらったり、研究室で「この授業に出ていたよね?」と話しかけてもらったりする機会が増え、少しずつ交流が広がっているのを感じています。来週からは、自分からも積極的に声をかけられるよう努力したいと思います。
研究室では顕微鏡を使った細胞観察に取り組んでいます。海藻の細胞を観察し、その数を数えたり、動いている細胞と動かない細胞を区別する方法を試したりしています。観察対象の細胞は非常に美しく、特に回転している細胞が個人的に印象に残っています。研究室の学生と顔を合わせる機会も増えてきました。新しい出会いが続き、名前を覚えるのに苦戦していますが、少しずつ覚えていければと思っています。


サンマルコス研修レポート③
3週目(9月6日〜9月12日)
週末はホストファミリーと家族が集まり、ピザ窯で焼いた手作りピザを楽しんだり、庭でバーベキューをしたりしました。ピザは生地から手作りし、窯の温度を調整しながら焼き上げる本格的なものでした。バーベキューではハンバーガーをいただき、準備を手伝いながらホストファミリーとの交流を深めました。日が長く20時頃に日が沈むため、夕方涼しくなってからの外での食事は気持ちが良いです。
また、プレゼント用のチョコレートを入れる箱を折る作業を手伝った際には、手際の良さに驚かれました。折り紙の文化が思わぬ場面で役立った瞬間でした。お礼にチョコレートをいただきました。夜にはホストファミリーやそのご友人と近くのプールに出かけました。日が暮れると気温が下がるため、プールが暖かく心地よく感じられました。


また、ホストファミリーと一緒にミュージカルを観に行きました。ホストマザーはミュージカルが大好きで、年に何度も観劇しているそうです。年末の旅行でもいくつか観る予定があると話してくれました。今回の作品は臓器移植をテーマにしており、事故による脳死判定から丸一日を描いた物語でした。重いテーマではありましたが、暗い雰囲気に偏ることなく、家族やレシピエントの葛藤も丁寧に表現され、最後には深く心を打たれる内容でした。目の前で繰り広げられる演技や歌は非常に迫力があり、ぜひまた観たいと思いました。観劇後にはスタンディングオベーションが行われ、日本との文化の違いを体験することもできました。

先週から本格的に始まった講義では、学生の方々と少しずつ会話を交わせるようになってきました。授業の前後に声をかけてもらい、日本についての思い出や訪問予定を話してくれる方も多いです。学生同士の会話に加わるのはまだ難しいものの、1対1であれば聞き返しながらやり取りできるため、少しずつ会話力がついてきていると感じます。来年東京を訪れる予定の学生さんからは、観光地や服装などについて相談され、楽しく話すことができました。また時折会話がスムーズにできていると感じられる瞬間があります。少しずつ自分の英語力の向上を感じられ、勉強のモチベーションとなっています。
研究室での活動も充実してきました。研究自体は思うように進まない部分もありますが、徐々に理解が深まり、自分の成長を実感しています。今週はフローサイトメトリーを使用するため、サファリパーク内にある研究所を訪れました。解析には時間がかかり、後日改めてサンプルを回収することになりました。残念ながら動物を見る機会はありませんでしたが、貴重な経験となりました。


さらに、キャンパス内で開催された「Coffee Hour」にも参加しました。月に一度、多国籍の学生が集うイベントで、飲み物やスナックを楽しみながらゲームを通して交流しました。多くの学生が参加していました。パーティーのような雰囲気で初対面の人ばかりだったため緊張しましたが、新たな人と出会う良い機会となりました。後日Coffee Hourで出会った学生さんに声をかけてもらうこともありました。少しずつですが、人とのつながりが広がっていることを実感できた出来事でした。
サンマルコス研修レポート④
4週目(9月13日〜9月19日)
週末には、日本人学生と一緒にカリフォルニア・アドベンチャーに行きました。日本のディズニーにもあるアトラクションがいくつかありましたが、最も驚いたのは待ち時間の短さです。日本では人気アトラクションの場合、長いときには3時間近く並ぶこともありますが、こちらでは最大でも1時間程度で、多くのアトラクションを楽しむことができました。また、日本人観光客も多く訪れており、園内には日本語表記のデザインも見られました。日本にある英語表記のように、海外の方にはこう映っているのだと気づくことができ、新鮮でした。
今週で短期留学の日本人学生が帰国してしまうため寂しさはありますが、とても仲良くなれたので帰国後に会う約束をしました。再会を楽しみにしつつ、残りの日々を大切に過ごしていきたいと思います。


また週末にはホストマザーと一緒に近所へハイキングに出かけました。車社会であるアメリカでは、意識的に運動を取り入れる必要があるため、ホストファミリーは普段からランニングやウォーキングなどを行っています。カリフォルニアは起伏に富んだ地形で、周囲には山や丘が数多くあります。今回登った山はかなり急な坂道でしたが、久しぶりの運動で気分をリフレッシュすることができました。高い場所まで登ったこともあり、天候にも恵まれて、近所の景色を一望することができました。

今週は通常の授業に加え、特別なプログラムもいくつかありました。一つは卒業生講話です。今年5月にバイオテックプログラムを修了した卒業生を招き、在学中の経験やインターンシップについて質疑応答形式でお話を伺いました。多くの学生が参加し、食事をとりながら交流する時間もありました。また、バイオテックプログラムの学生を集めたミーティングにも参加しました。そこでもピザが提供され、食事をしながら授業に参加するという、日本ではあまり経験できないスタイルを体験しました。

アメリカの大学院は年齢層が幅広く、働きながら学ぶ学生も多いため、講義は夕方以降に開講されます。勤務先によっては大学院進学を支援する制度があり、授業のために時短勤務をすることも可能だそうです。そのため、子育てや仕事と両立しながら通う方もいます。今週はサイエンスコミュニケーションの講義も見学しました。この授業ではスピーチ練習に加え、原稿の書き方やAIの活用についても学んでいました。特にOpenAIを使って原稿の添削を行い、フィードバックまでの時間を短縮している点が印象的でした。日本と比べてAIの活用が進んでおり、仕事や授業内で活用することも多々あるそうです。その講義は日本人の先生が担当されており、英語学習法やアメリカで活躍するためのアドバイスをいただきました。また、アメリカは変化のスピードが速く、プロジェクトリーダーは年齢や役職に関係なく“適任”と判断された人が務めるそうです。そうした柔軟さが魅力であり、面白さだとおっしゃっていました。さらに、研究室の教授であるホストマザーは他の研究室の学生についても、住んでいる場所や仕事、趣味までも知っており、日本と比べて先生との距離が近く、カジュアルな関係性が築かれていることを感じました。積極的なコミュニケーションはとても良い文化だと思い、帰国後にぜひ実践してみたいと考えています。
また、バイオテックプログラムの学生に誘われ、DAVE & BUSTER’S というレストラン・バー・ゲームセンターが一体化した施設に行きました。子どもの誕生日パーティーなどにもよく利用される場所だそうです。食事をしながら会話を楽しみ、ゲームでも盛り上がりました。普段は講義で関わる機会のない学生とも交流でき、とても良い機会になりました。みなさん積極的に話しかけてくれ、私にも関心を持って接してくれる姿勢が嬉しかったです。ここでもコミュニケーションの文化を感じられました。徐々に質問に答えられるようになってきたので、次週は自分から質問できるよう意識していきたいと思います。

サンマルコス研修レポート⑤
5週目(9月20日〜9月26日)
今週はホストマザーに連れられて、日本食を扱うスーパーマーケットへ行きました。そのお店には韓国・中国・日本の商品が揃っており、見慣れた食材も多く販売されていました。こちらに来てからはパンやパスタ中心の食生活だったため、お米を購入して調理しました。鍋で炊飯するのは初めてで、最初はうまく炊けませんでしたが、2回目以降はきれいに炊き上げることができました。日本のお米と比べると水分や甘みが少なく、さらっとした食感で、白米として食べるよりもリゾットなど味を加えて調理するとより美味しくいただけると感じました。

作成した朝食

作成したリゾット
また、ホストファミリーと近所のワイナリーを訪れ、食事を楽しみました。周囲には一面にブドウ畑が広がり、この地域には数多くのワイナリーがあります。樽が並ぶ店内では試飲や購入ができ、外にはキッチンカーも出ていて食事も楽しめました。私たちは食事をしながら会話を楽しみ、会場では音楽に合わせて多くの人が踊っており、とても賑やかな雰囲気でした。ホストファミリーがビーツの味について議論していた場面では積極的に発言はできなかったものの、大まかな内容を聞き取ることができ、自身の成長を実感する瞬間となりました。

ワイナリーの飲食スペース

ワイナリー
また、時間を見つけて近所をウォーキングしました。日本とは異なる街並みにワクワクしながら歩き、開けた場所からは綺麗な景色を眺めることもできました。曇り空で日差しは強くなかったものの、坂道が多いため汗ばむほどの運動になりました。車移動が中心の生活のなかで、久しぶりに長距離を歩き良い運動になりました。大学周辺の街並みとは異なり、落ち着いた雰囲気です。多くの家にアメリカの国旗が飾られているのが印象的です。また、ハロウィンが近くなってきたため、多くの家やお店でかぼちゃやおばけなどが飾られており、街全体からハロウィンが近づいてきていることがわかります。

カフェで見かけたかぼちゃのイラスト
研究室では新しい取り組みとして、寒天培地を用いた菌の培養を行いました。日本でも寒天培養は行ってきましたが、培地作製後に表面へ菌を塗布していました。今回は培地の中に菌を混ぜ込む方法で培養を行い、無事にコロニーが形成されました。今後はさらに培養を重ねていく予定です。 また、DNA抽出にも挑戦しました。緑色に見えるのがDNAで、初めての方法に取り組むことができました。遠心分離を一晩かけて行ったのが特に印象に残りました。
培養中の細胞

抽出したDNA
サンマルコス研修レポート⑥
6週目(9月27日〜10月3日)
今週はサンディエゴにあるコロナドとオールドタウンというメキシコ文化の色濃い場所を訪れました。かつてこの地域はメキシコの領地だったため、現在のカリフォルニア南部にはメキシコ文化が今も多く残っているそうです。街全体がカラフルで、多くの人で賑わっていました。チカノパークという公園の柱や橋の側面には、メキシコのミュージシャンや著名人を描いたカラフルなイラストが数多くあり、ホストマザーの解説を聞きながら一緒に見て回りました。ホストマザーが以前日本語を見かけたと言っていたため、一緒に探してみましたが見つけることはできませんでした。

チカノパーク

メキシコ料理
メキシコでは、日本のお盆にあたる「死者の日(Día de los Muertos)」が11月2日にあります。そのため街中には、ドレスアップしたガイコツの人形がたくさん飾られていました。ハロウィンも近いことから、お化けやかぼちゃの装飾も多く、映画『リメンバー・ミー』の世界そのもののようで、とても感激しました。日が沈むと街は一気に暗くなり、カラフルな装飾がライトアップされてより幻想的な雰囲気に包まれました。この日はメキシコ料理をいただき、お肉や野菜、お米をトルティーヤに包んで食べました。普段あまりメキシコ料理を食べる機会がなかったため新鮮でしたが、とても美味しかったです。

街の様子

ライトアップされたガイコツ
また、Catalentという医薬品などの開発・製造を行う企業を見学しました。活躍する女性社員の方々によるパネルディスカッションがあり、キャリアパスや職場環境についてさまざまなお話を伺いました。研究所とオフィスを見学した後、社員の方々と昼食を取りながら交流しました。その際、娘さんの出産報告を受けて喜んでいる方がいて、職場全体の温かくオープンな雰囲気が印象的でした。
また、送迎してくれた学生さんがステップファミリーの一員であることを教えてくれました。ステップファミリーとは、親の再婚により血縁関係のない家族が共に暮らす家庭のことを指すそうです。気になって調べてみたところ、アメリカでは養子や家族の形に対して非常にオープンな文化が根付いており、実際に「自分は養子だ」と公言している人にも出会いました。日本ではあまり見られない価値観で、初めは驚きましたが、こうしたオープンさはとても良い文化だと感じました。
そして今週から、最終週に行われるファイナルプレゼンテーションに向けて発表資料の作成が始まりました。海外研修の終わりが近づいていることを実感し、月日の流れの早さを感じます。残りの3週間を一日一日大切に、できる限り有意義に過ごしたいと思います。
サンマルコス研修レポート⑦
7週目(10月4日〜10月10日)
週末には、ビーチの近くにある山をハイキングしました。途中には地層や断層が見られる場所があり、自然の造形を間近に感じることができました。山頂からは海を一望でき、非常に美しい景色を眺めることができました。歩いている途中で、お皿を重ねたような形の装置を見つけ、ホストマザーに尋ねたところ、カブトムシを集めるための装置だと教えてくれました。アメリカではカブトムシは日本のようにペットとして人気があるわけではなく、主に研究目的で集められているそうです。日本では子どもがカブトムシを捕まえて飼うことがあると話したところ、とても驚かれました。その一方で、研究室の学生さんから「さっき見たカマキリの写真を見て!」と嬉しそうに見せられることもあり、昆虫への興味の持ち方や価値観の違いを感じました。ちなみにカマキリは英語で“praying mantis”といい、日本語では鎌、英語ではお祈りのポーズに見立て名付けられていることを知りました。
また、この地域には「Torrey pine(トーリーパイン)」という松の木が多く自生しています。この松は非常に希少で、自然の状態で生えている場所は限られているそうです。今回訪れたエリアはTorrey pineの自然保護区の中にあり、貴重な松林を間近で見ることができました。松といえば日本ではお正月の門松を連想しますが、アメリカの海沿いに松が生えている光景は新鮮で、不思議な感覚でした。

Torrey pineの木

山からの景色
最終週に向けて、プレゼンテーションの準備が本格的に始まりました。発表は2回あり、1つは研究や学んだ内容について、もう1つは留学生活で感じたことや経験を振り返るものです。この2ヶ月間を振り返る良い機会になると感じています。先日スピーチの練習をしていた際、自分の発音が以前よりも明確になっていることに気がつきました。まだ完璧ではなく、うまく伝わらないことも多いですが、確実に成長していると実感しています。また、耳が英語に慣れてきたことで、会話の聞き取りも以前より格段にできるようになりました。初めのころは1対1の会話でも、ゆっくり話してもらわないと理解できませんでしたが、最近は複数人での会話にも少しずつ参加できるようになってきました。授業の前後や休み時間には学生同士で話すことも多く、自分の意見を伝えたり、相手に質問を返したりと、自然な会話ができる場面が増えています。そうした瞬間に、自身の成長を強く感じます。コミュニケーションが取れると話す楽しさを感じられるため、残りの2週間はたくさんコミュニケーションをとることを目標に過ごそうと思います。
サンマルコス研修レポート⑧
8週目(10月11日〜10月18日)
今週は「ベビーシャワー」という、出産を控えた妊婦さんの安産を祈り、お祝いするイベントがありました。食事を囲みながらゲームをしたり、ギフトを渡したりするパーティーです。今回はホストマザーが学生さんたちを招待し、その中の一人のお祝いをしました。来月には双子が生まれるそうです。
参加者の中には日本語を少し話せる人とスペイン語を話せる人がいて、3人で日本語・英語・スペイン語を教え合いながら会話を楽しみました。
ホストマザーは主催者として準備に追われていたため、私も一緒に手伝いました。料理を作ったり、ハロウィンの飾り付けをしたりして準備を進めました。翌日、「あなたがいなかったら時間内に準備が終わらなかった、ありがとう」と言われ、とても嬉しかったです。さらに、「12月のホームパーティーのとき、あなたがいないのが寂しい」と言ってもらい、胸が温かくなりました。いつかまた一緒にパーティーの準備をしたいです。

作成したキッシュ

作成中の桃のコンポート
また、最終週のプレゼンテーションに向けて、資料作りやスピーチの練習を本格的に始めました。発表は2回あり、1回目は研究内容を中心に、2回目は留学を通して感じたことや得たことをテーマとしています。資料作成の過程では、日本との違いを感じる場面がありました。日本ではスライドごとに内容をまとめた短いタイトルをつけ、文章は箇条書きで簡潔にまとめることが多いですが、こちらではタイトルの部分に「そのスライドで最も伝えたいこと」を一文で示し、本文では写真や図を用いて根拠を示すという方法をとっていました。スタイルの違いに少し戸惑いながらも、資料作りに励みました。
いよいよ来週は最終週です。プレゼンテーションの練習に力を入れつつ、残りの時間を存分に楽しみたいと思います。
サンマルコス研修レポート⑨
9週目(10月19日〜10月27日)
今週は、バイオテック専攻の学生たちとハロウィンパーティーを行いました。学生のアパートに約15人が集まり、持ち寄った料理やお菓子、お酒などを楽しみました。参加者全員がさまざまな仮装をしており、とても華やかで活気のあるパーティーでした。ゲームをしたり映画を観たりと賑やかな時間が続き、笑顔の絶えないひとときとなりました。
また、企業訪問にも参加しました。訪問先では、会社の事業内容や製品紹介のほか、パネルディスカッションや座談会が行われました。座談会では質問をすることは難しかったものの、少人数での会話だったため内容を理解しながら会話に参加することができました。話を振られた際には自分の考えを述べることもでき、1回目の企業訪問のときと比べて英語でのコミュニケーション力の向上を実感しました。
最終週には、この海外研修の集大成となるプレゼンテーションが2回行われました。1回目の発表では、訪れた場所や体験したイベント、異文化交流を中心に紹介し、自分にとって学びになったことや難しかったことを振り返りました。文化の違いを肌で感じることができたのは、大きな成長につながる貴重な経験でした。質疑応答にも落ち着いて対応できたことで、自信を持つことができました。
2回目の発表は研究内容をテーマとしたプレゼンテーションで、サイエンスコミュニケーションの授業時間をいただいて実施しました。その講義を履修していない学生やホストファザーも聴講に訪れ、会場には約30人が集まりました。多くの聴衆を前に緊張しましたが、友人たちから温かい励ましの言葉をもらい、落ち着いて発表に臨むことができました。発表後には寄せ書き入りのメッセージカードやたくさんのプレゼントをいただきとても嬉しかったです。英語で研究発表を行い、多くの人に聞いてもらえたこと、そして努力を評価してもらえたことは、大きな自信となりました。
この研修を通して、自分の課題を明確にしながらも、大きな成長を実感することができました。初めの頃は英語に自信が持てず、思うように話せないことが多かったものの、少しずつ間違いを恐れずに話せるようになり、聞き返されても伝えようとする姿勢が身につきました。まだ十分な英語力があるとは言えませんが、この経験を糧に、帰国後も学習を続けていきたいと思います。
本件に関するお問い合わせ
- 東京薬科大学 国際課
-
- 042-676-7306(8:45~17:00 月~金、祝日は除く)
- 問い合わせフォーム
- 〒192-0392 東京都八王子市堀之内1432-1





